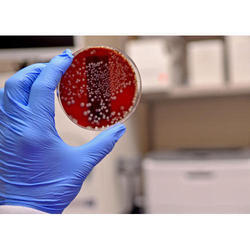
> </div>
<div class=

Pathogen Testing Service
Description / Specification of Pathogen Testing Service
We are involved in offering a wide range of Pathogen Testing Service to our most valued clients. Our range of these are widely appreciated by our clients which are situated all round the nation. We offer our range of it at most affordable prices.
We introduce ourselves as an eminent trader and supplier of an extensive array of Pathogen Testing Service. Prior to dispatch, our quality controllers run numerous tests on the entire range on various parameters of quality and durability. The offered equipment is manufactured using superior quality components with the aid of sophisticated techniques at the vendors' end. Moreover, our precious clients can purchase it in different technical specifications at reasonable price from us within promised time frame.
Features:
Sturdy design
Highly durable
Application specific design
